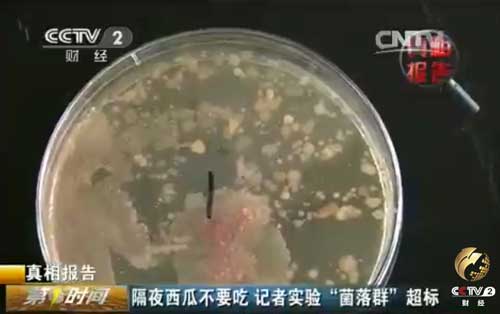

西瓜是消暑解渴的好水果。生活中,我们都曾有过这样的经历,西瓜一顿吃不完,套上保鲜膜往冰箱里一放,第二天再吃。可是,最近网上一个流传甚广的段子让人很紧张。说是一家三口由于吃了隔夜的西瓜均病倒。那隔夜的西瓜到底能不能吃呢?来看央视财经《第一时间》的真相报告。

为了验证隔夜西瓜是否能吃,记者将半个西瓜用保鲜膜包好放入冰箱进行冷藏,隔了一夜,记者带着这个西瓜来到江苏淮安市第四人民医院的细菌实验室,请检测人员进行检测。

工作人员分别在西瓜切面的表层、表层下4厘米处、表层下8厘米处取样,每处取样1克,捣碎后放入培养基中,分别标明1、2、3号,放入培养箱。48个小时后,令人有些震惊的实验结果出来了。检测人员告诉记者,经过48小时的培育之后,他们发现这三个样本都培养出了细菌,特别是一号样本,也就是是从西瓜的表层抽取部分的细菌基本上已经覆盖了培养皿的底部。
1号培养皿中分布着密密麻麻的菌落群,就连实验人员也感到吃惊,他们表示其中的细菌数量已经难以数清,需要以亿为单位计算;2号和3号培养皿中的菌落群比1号少了不少,但也难以计算。江苏淮安市第四人民医院细菌实验室检验师纪小亭告诉我们,培养过后可以看到,西瓜样本中的细菌大多数都是阴性杆菌和阳性球菌,但是也不能排除有肠道致病菌生长,对于胃肠道功能不好的的人来说,吃了这些东西以后,可能会引起腹泻、肠胃炎等,所以建议大家尽量不要食用过夜的西瓜,即使是冷藏过以后也不能确保安全。
来源:央视网
更新时间:2014年07月08日 09:30
视频简介:真相报告:隔夜西瓜不要吃,记者实验“菌落群”超标。